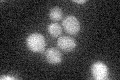
YLR079W
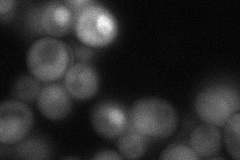
YLR079W
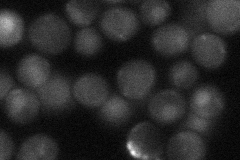
YLR079W

View description
Inhibitor of Cdc28-Clb kinase complexes that controls G1/S phase transition, preventing premature S phase and ensuring genomic integrity; phosphorylation targets Sic1p for SCF(CDC4)-dependent turnover; functional homolog of mammalian Kip1
Localization:
Intensity:
Fold change:
Significance:
-
C’ GFP library in SD
below threshold16.62 -
N' NOP1pr-GFP in SD
cytosol,nucleus50.9696 -
N' TEF2pr-mCherry in SD

cytosol10.6754 -
N' NATIVEpr-GFP in SD
nucleus30.1975 -
N' TEF2pr-VC and Cyto-VN in SD

#N/A0 -
C’ GFP library in SD+DTT

cytosol17.591.05No -
C’ GFP library in SD+H2O2

cytosol17.221.03No -
C’ GFP library in Starvation Media

cytosol16.711No -
C’ GFP library on the background of Pup2-DaMP

below threshold -
C’ GFP library on the background of CCT mutant

below threshold17.10491.02849No
